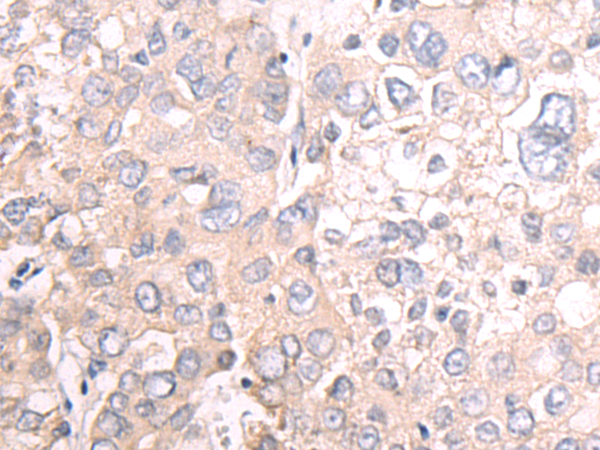

-
分类: 科研抗体货号: P12546别名: TGD; ABC1; CERP; ABC-1; HDLDT1; HPALP1; HDLCQTL13应用: IHC反应种属: Human, Mouse
-
分类: 科研抗体货号: P12527别名: HTK; MYK1; HFASD; CMAVM2; LMPHM7; TYRO11应用: IHC反应种属: Human, Mouse
-
分类: 科研抗体货号: P12507别名: CX45; GJA7应用: IHC反应种属: Human, Mouse, Rat
-
分类: 科研抗体货号: P12545别名: HTR2; 5-HT2A应用: WB,IHC反应种属: Human, Mouse
-
分类: 科研抗体货号: P12526别名: ELK; NET; Hek6; EPHT2应用: IHC反应种属: Human, Mouse, Rat
-
分类: 科研抗体货号: P12504别名: GPR2应用: IHC反应种属: Human, Mouse
-
分类: 科研抗体货号: P12544别名: S12; 5-HT1B; HTR1D2; HTR1DB; 5-HT1DB应用: IHC反应种属: Human
-
分类: 科研抗体货号: P12525别名: ECK; CTPA; ARCC2; CTPP1; CTRCT6应用: IHC反应种属: Human, Mouse
-
分类: 科研抗体货号: P12535别名:应用: IHC反应种属: Human
-
分类: 科研抗体货号: P12524别名: EP3; EP3e; EP3-I; EP3-II; EP3-IV; PGE2-R; EP3-III应用: IHC反应种属: Human

鄂公网安备42018502007531号
鄂公网安备42018502007531号

